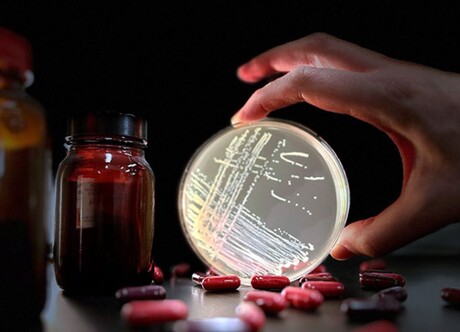

'Low-risk' antibiotic linked to rise of dangerous superbug
A new study led by The Peter Doherty Institute for Infection and Immunity and Austin Health has challenged the long-held belief that rifaximin — an antibiotic commonly prescribed to patients with liver disease — poses a low risk for causing antibiotic resistance. Indeed, the antibiotic appears to have led to the global emergence of an almost untreatable form of vancomycin-resistant Enterococcus faecium (VRE), which frequently causes serious infections in hospitalised patients.
The researchers’ study, which was published in the journal Nature, demonstrated that rifaximin usage is driving resistance to daptomycin, one of the last effective antibiotics against VRE infections. The rise of this antimicrobial-resistant superbug highlights the critical need for a deeper understanding of the negative impacts of antibiotic use.
The eight-year study drew on several disciplines, including molecular microbiology, bioinformatics and clinical science. Using large-scale genomics — the study of an organism’s DNA makeup — the scientists were able to identify changes in the DNA of daptomycin-resistant VRE that were absent in susceptible strains. Subsequent laboratory experimentation and clinical studies showed that rifaximin use caused these changes and resulted in the emergence of daptomycin-resistant VRE.
“We’ve shown that rifaximin makes VRE resistant to daptomycin in a way that has not been seen before,” said Dr Glen Carter, a Senior Research Fellow at the Doherty Institute and senior author on the study.
“It is also of concern that these daptomycin-resistant VRE might be transmitted to other patients in the hospital; a hypothesis that we are presently investigating.”
Dr Adrianna Turner, a Research Officer at the Doherty Institute and first author of the study, said rifaximin triggers specific changes in an enzyme called RNA polymerase within the bacteria. These changes ‘upregulate’ a previously unknown gene cluster (prdRAB), leading to alterations in the VRE cell membrane and causing cross resistance to daptomycin.
“When bacteria become resistant to an antibiotic, it’s a bit like gaining a new ability in a video game, like super-speed,” Turner said. “But when exposed to rifaximin, the VRE bacteria don’t just get one boost — they gain multiple abilities, like super-speed and super-strength, allowing them to easily defeat even the final boss, which in this case is the antibiotic daptomycin.
“In other words, rifaximin doesn’t just make bacteria resistant to one antibiotic; it can make them resistant to others, including critical last-resort antibiotics like daptomycin.”
Associate Professor Jason Kwong, Infectious Diseases Physician at Austin Health and lead investigator of the clinical studies, emphasised two critical implications of the findings.
“Firstly, clinicians must exercise caution when treating VRE infections in patients who have been taking rifaximin, since daptomycin’s efficacy may be compromised, necessitating laboratory verification before use,” Kwong said.
“Secondly, the findings underscore the importance of regulatory bodies considering ‘off-target and cross-class’ effects when approving new drugs. For antibiotics, this means understanding whether exposure to one agent, like rifaximin, could induce resistance against other antibiotics — even those that work differently.
“Rifaximin is still a very effective medication when used appropriately and patients with advanced liver disease who are currently taking it should continue to do so. But we need to understand the implications going forward both when treating individual patients and from a public health perspective.”
Scientists search for cystitis pain 'off switch'
By targeting certain pain receptors in the bladder, Australian scientists believe that the...
Australia's first cases of H5 avian influenza confirmed
Positive results for H5 avian influenza (bird flu) have been confirmed in two seabirds found in...
AusBiotech partners with Tenmile
Designed to support Australia's homegrown life sciences innovation, AusBiotech has announced...




